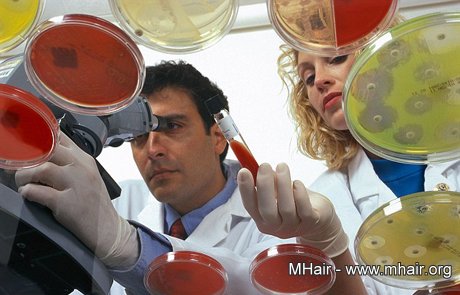

中评社北京3月23日电/很多中年男性都担心自己脱发,有数据显示50岁的男性出现脱发的概率是50%,而随着
年龄的增长,这一数据还会增加。近日美国科学家表示,他们发现了阻止男性头发再生的一种蛋白质,而抑制该蛋白质的药物已在此前研发出来治疗哮喘症。目前科
学家们正据此研究一种生发乳或者药剂,预计在5年内新药物将被推入市场。
中国日报网报道,这一突破性的研究成果是美国宾夕法尼亚大
学科学家做出的。他们之前发现脱发的人头皮上也有一种促进头发生长的细胞,而
PDG2则是阻止该细胞发育的一种蛋白质。随后研究人员又对脱发男性头皮进行仔细分析,发现头发稀少处蛋白质PDG2的含量是头发茂密处的3倍。
研究人员在小白鼠身上做了相关实验,结果显示这种蛋白质抑制了老鼠毛发的生长。所以他们进一步推断抑制PDG2的含量,就能够有效制止男性脱发。
据不完全统计,英国目前有740万已经秃头或正在脱发的男性,目前的治疗方法很有限,包括进行头发移植等,但移植头发的过程非常痛苦且成功率也没有保证。宾夕法尼亚大学研发的这种治疗方法不仅能抑制脱发或许还能帮助男性头上长出新发。
针对抑制PDG2含量过高的药物,制药公司之前已经开始研发并制成了药片,目前进入测试阶段,但为了能有效进行局部治疗,该药物需要制作成适合涂抹的膏体或制剂,所以研究人员还需投入更多精力,这一过程估计在5年内可完成。
参与该项研究的乔治.科察列斯博士说:“这种方法对于治疗秃头将非常有帮助,我们已经确定它可以抑制脱发,但对于长出新头发的疗效目前尚不确定。”


